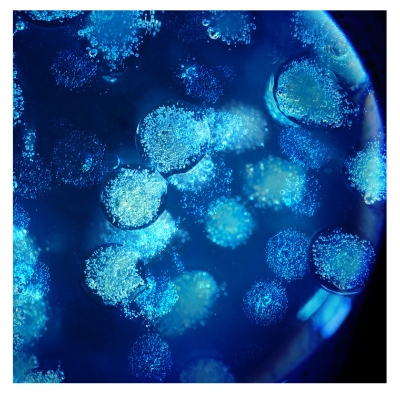
Biotherm Biovergetures Gel-Crème Anti-Vergetures 150 ml

Biotherm Biovergetures Gel-Crème Anti-Vergetures 150 ml

|
|
Livraison entre 3 et 4 jours à 3,90 € Offerte dès 49 € |
|
|
Livraison entre 3 et 4 jours à 6,95 € Offerte dès 59 € |
|
|
Livraison entre 1 et 2 jours à 17,95 € |









Biotherm Biovergetures Gel-Crème Anti-Vergetures 150 ml est un soin qui favorise la prévention et active la réduction des vergetures.
Riche en agents hydratants, en huiles végétales (karité, soja) et en algo silicium, ce gel améliore la résistance et l'élasticité de la peau pour faciliter son étirement pendant la grossesse.
Il active la réduction des vergetures existantes en diminuant la taille, la profondeur et la coloration.
Non gras, ce gel-crème délicatement parfumé laisse la peau fraîche et lisse. Il permet de s'habiller rapidement et ne tache pas.
Testé sous contrôle médical.
Fabriqué en France.
Traitement préventif : appliquer chaque jour sur les zones à vergetures (seins, ventre, cuisses), à partir du 4ème mois de la grossesse.
Traitement curatif : appliquer quotidiennement pendant 2 ou 3 mois sur les zones ciblées.
Ne pas appliquer sur le visage. Éviter d'appliquer le produit juste avant l'allaitement. Nettoyer le sein avant d'allaiter. Ne pas appliquer en cas de crevasses ou de fendillements.
Aqua/Water/Eau, Dimethicone, Glycerin, Propylene Glycol, Stearoxy Dimethicone, Myreth-3 Myristate, Propylene Glycol Diethylhexanoate, Glycine Soja Oil/Soybean Oil, Hydroxyproline, Butyrospermum Parkii Butter/Shea Butter, PEG-100 Stearate, Carbomer, Hydrogenated Lecithin, Glyceryl Stearate, Methylsilanol Mannuronate, Sodium Hydroxide, Sodium Stearoyl Glutamate, Cholesterol, Disodium EDTA, Tocopheryl Acetate, Phenoxyethanol, Chlorphenesin, CI 77491/Iron Oxides, CI 77492/Iron Oxides, Linalool, Eugenol, Benzyl Alcohol, Benzyl Benzoate, Benzyl Salicylate, Dimethiconol, Sodium Hydroxide, Parfum/Fragrance.
| Code EAN | 3367729008128 |
| Forme | Gel-crème |
| Présentation | Tube |
| Contenance | 150 ml |

Découvrir la marque

Biotherm est une marque renommée pour ses produits de soin innovants et efficaces. Découvrez la gamme complète de Biotherm sur Cocooncenter et trouvez le produit qui correspond à vos besoins spécifiques.





